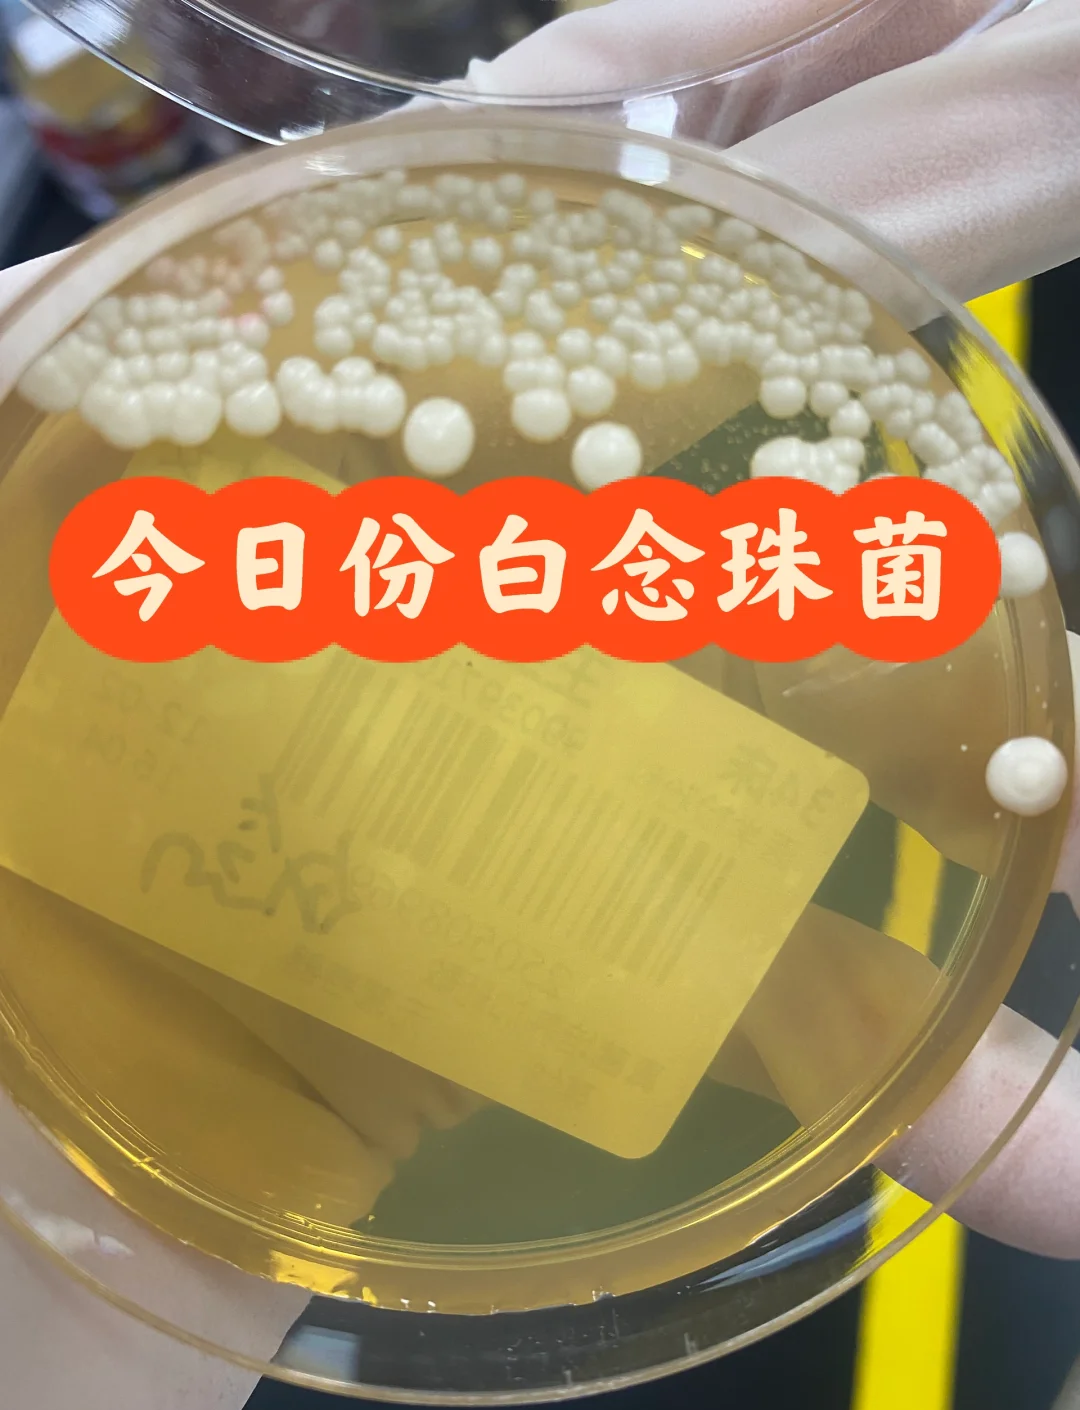
雪榕生物发布自主选育的白色金针菇新菌种

中证报中证网讯(记者 乔翔)2026年1月4日,雪榕生物发布自主选育的白色金针菇新菌种X139。公司表示,这一成果标志着我国成功攻克白色金针菇种源难题,打破了该领域对国外菌种的依赖。X139菌种已获得国家发明专利,这为技术创新成果提供了坚实的法律保障,也为行业可持续发展奠定坚实基础。

图片来源于网络,如有侵权,请联系删除
据介绍,自2025年6月实现产业化应用以来,新菌种X139已支撑雪榕生物实现日产1200吨的生产规模,约占全国金针菇工厂化生产总量的30%。凭借自主菌种培育的高品质产品,雪榕金针菇已成功进入日本市场,实现了产品输出的重要突破。

图片来源于网络,如有侵权,请联系删除
雪榕生物表示,将秉持“开放、合作、共享、共生、共赢、共荣”的理念,积极推动自主知识产权菌种在行业内的规范应用,计划未来将国产优质菌种的行业覆盖率提升至70%以上,让国家育种攻关成果惠及全行业,共同提升中国白色金针菇产业的国际竞争力。
图片来源于网络,如有侵权,请联系删除
雪榕生物创始人杨勇萍表示,此次突破是新起点,公司将持续加大研发投入,把成功经验拓展至更多食用菌品种。
转载请注明:博客金融网 » 企业快讯 » 雪榕生物发布自主选育的白色金针菇新菌种










